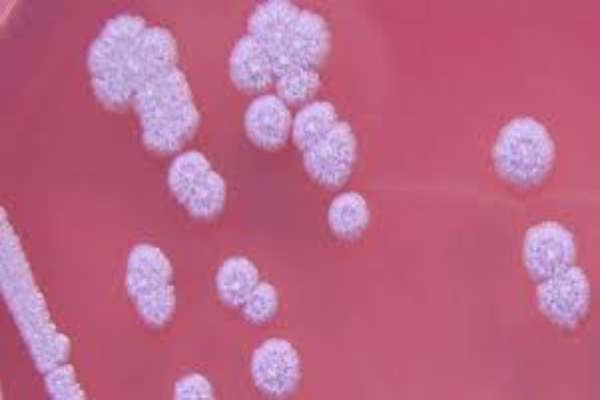

Мелиоидоз
Что такое мелиоидоз?
Мелиоидоз (melioidosis) (ложный сап, сапоподобное заболевание, болезнь Стантона, сап Рангуна, болезнь Флетчера, пневмоэнтерит) – инфекционная болезнь животных и человека, характеризующаяся лихорадкой, септицемией, образованием абсцессов в легких, печени, селезенке, почках и других органах, на коже – язв. Относится к антропозоонозам, входит в группу так называемых особо опасных инфекций.
Где регистрируются очаги заболевания? Кто находится в зоне риска?
Болезнь регистрируется в ряде стран Юго-Восточной Азии(Бирма, Индия, Индонезия, Вьетнам, Камбоджа, Таиланд и некоторые другие), на островах Шри-Ланка и Мадагаскар, в Австралии, Южной Америке, Панаме, США.
К мелиоидозу восприимчивы овцы, козы, лошади, крупный рогатый скот, свиньи обезьяны, собаки, кошки, дикие грызуны; из лабораторных животных – кролики, крысы и белые мыши. Экономический ущерб от мелиоидоза невелик, т. к. это заболевание у сельскохозяйственных животных встречается спорадически.
Однако мелиоидоз очень опасен для людей. Человек может заражаться при поедании пищи, загрязненной возбудителем болезни, при разделке туш животных, инфицированных Bact. whitmori, а также при использовании молока от больных животных. Холоднокровные и птицы к мелиоидозу невосприимчивы.
Что является возбудителем мелиоидоза? Кто является переносчиком?
Возбудитель болезни — Pseudomonas pseudomallei,известен также под следующими названиями: Malleomyces pseudomallei, Pfeifferella pseudomallei, Actinobacillus pseudomallei, Whitmorella pseudmallei, Loefflerella Mhitmori и др. Это нежная, тонкая палочка с закруглёнными концами, размером 2—6 X 0,5—1 мкм, встречаются нитевидные формы длиной 15— 20 мкм; грамотрицательная, подвижная. Хорошо растёт на обычных питательных средах при t 37,5˚C, аэроб. Возбудитель мелиоидоза имеет антигенное родство с возбудителем сапа. Нагревание до t 56˚C убивает бактерию через 10—15 мин;1%-ный раствор фенола, 0,1%-ный раствор формальдегида — через 24 ч; на холоде (—4 °С) она погибает через 2—3 недели. Устойчива к высушиванию. В воде сохраняет жизнеспособность до 44 суток, в кале — до 27, в моче — до 17 суток
.
Источником возникновения инфекции являются больные животные, которые выделяют возбудителя во внешнюю среду с истечениями из носа, гноем кожных язв, мочой, испражнениями. Факторами передачи инфекции являются, почва, вода, корма и другие контаминированные выделениями инфицированных животных объекты внешней среды. Резервуаром инфекции в природе являются грызуны (крысы, мыши и др.), у которых болезнь может протекать хронически. Заражение происходит чаще алиментарным и аэрогенным путями, реже через кожу, возможен перенос бактерии блохами, обитающими на крысах, в организме которых бактерии сохраняются до 50 дней.

Какие наблюдаются клинические признаки?
Инкубационный период болезни длится 3-10 дней. Течение болезни острое, подострое и хроническое. У овец и коз отмечается кашель, истечения из носа, нервные симптомы. Для лошадей и крупного рогатого скота характерно относительно доброкачественное течение болезни, на месте проникновения возбудителя образуется флегмона, наблюдается кратковременная лихорадка, гнойные выделения из носовой полости, абсцессы во внутренних органах.
На основание чего ставится диагноз?
При постановке диагноза важно не ошибиться, и дифференцировать мелиоидоз от сапа. Большинство авторов отмечают, что по клинической картине и патологоанатомическим изменениям поставить диагноз на мелиоидоз довольно трудно. Необходимо провести бактериологическое и особенно биологическое исследование материала. Во всех подозрительных случаях делают посевы мочи, крови, экссудата или содержимого абсцесса для выделения чистой культуры Bact. whitmori с последующей проверкой ее биохимических свойств.
Кроме того, используют метод биологической пробы. Для этого заражают инфицированным материалом (кровь, моча, гной из абсцессов лабораторных животных, лучше морских свинок-самцов). Для заражения последних достаточно втереть патологический материал в скарифицированную кожу или ввести небольшие дозы его под кожу или в брюшную полость.
Существует ли лечение мелиоидоза? Каковы меры профилактики?
Препаратов для химического лечения мелиоидоза нет. При легких формах заболевания проводят симптоматическую терапию, применяют антибиотики и строго соблюдают меры личной безопасности при контактах с больными животными. Лечение зараженных животных в тяжелой форме нецелесообразно, т. к. мелиоидоз опасен для человека. Трупы павших или намеренно забитых животных уничтожают, придерживаясь мер личной гигиены. Уничтожение трупов происходит путем сжигания. Переносчиками мелиоидоза считаются грызуны, и кровососущие насекомые — паразиты грызунов. Следовательно меры профилактики должны быть направлены на борьбу с грызунами. Также, тяжесть течения мелиоидоза зависит от общего состояния организма животного. Поддержание иммунитета сводится к составлению правильного рациона, обеспечению достаточного моциона и соблюдению норм ветеринарной гигиены в помещениях для животных. Необходимо следить за чистотой корма и воды, не допускать их загрязнения выделениями грызунов.
Written by
Arina TARAN
BreedsMore
IllnessesMore
Forage cropsMore
Патологическая физиология голодания Arina TARAN
Дефицит фосфора (гипофосфатемия) Hipofosfatemi Arina TARAN
Какие бывают кормораздатчики для ферм КРС? Irina Makarova
Кормушки для овец Diana Myakisheva
Питание домашних коз: что едят, виды корма и правила кормления Alina Arslantürk
Важность минералов питании сельскохозяйственных животных Irina Makarova

Что такое мелиоидоз?
















